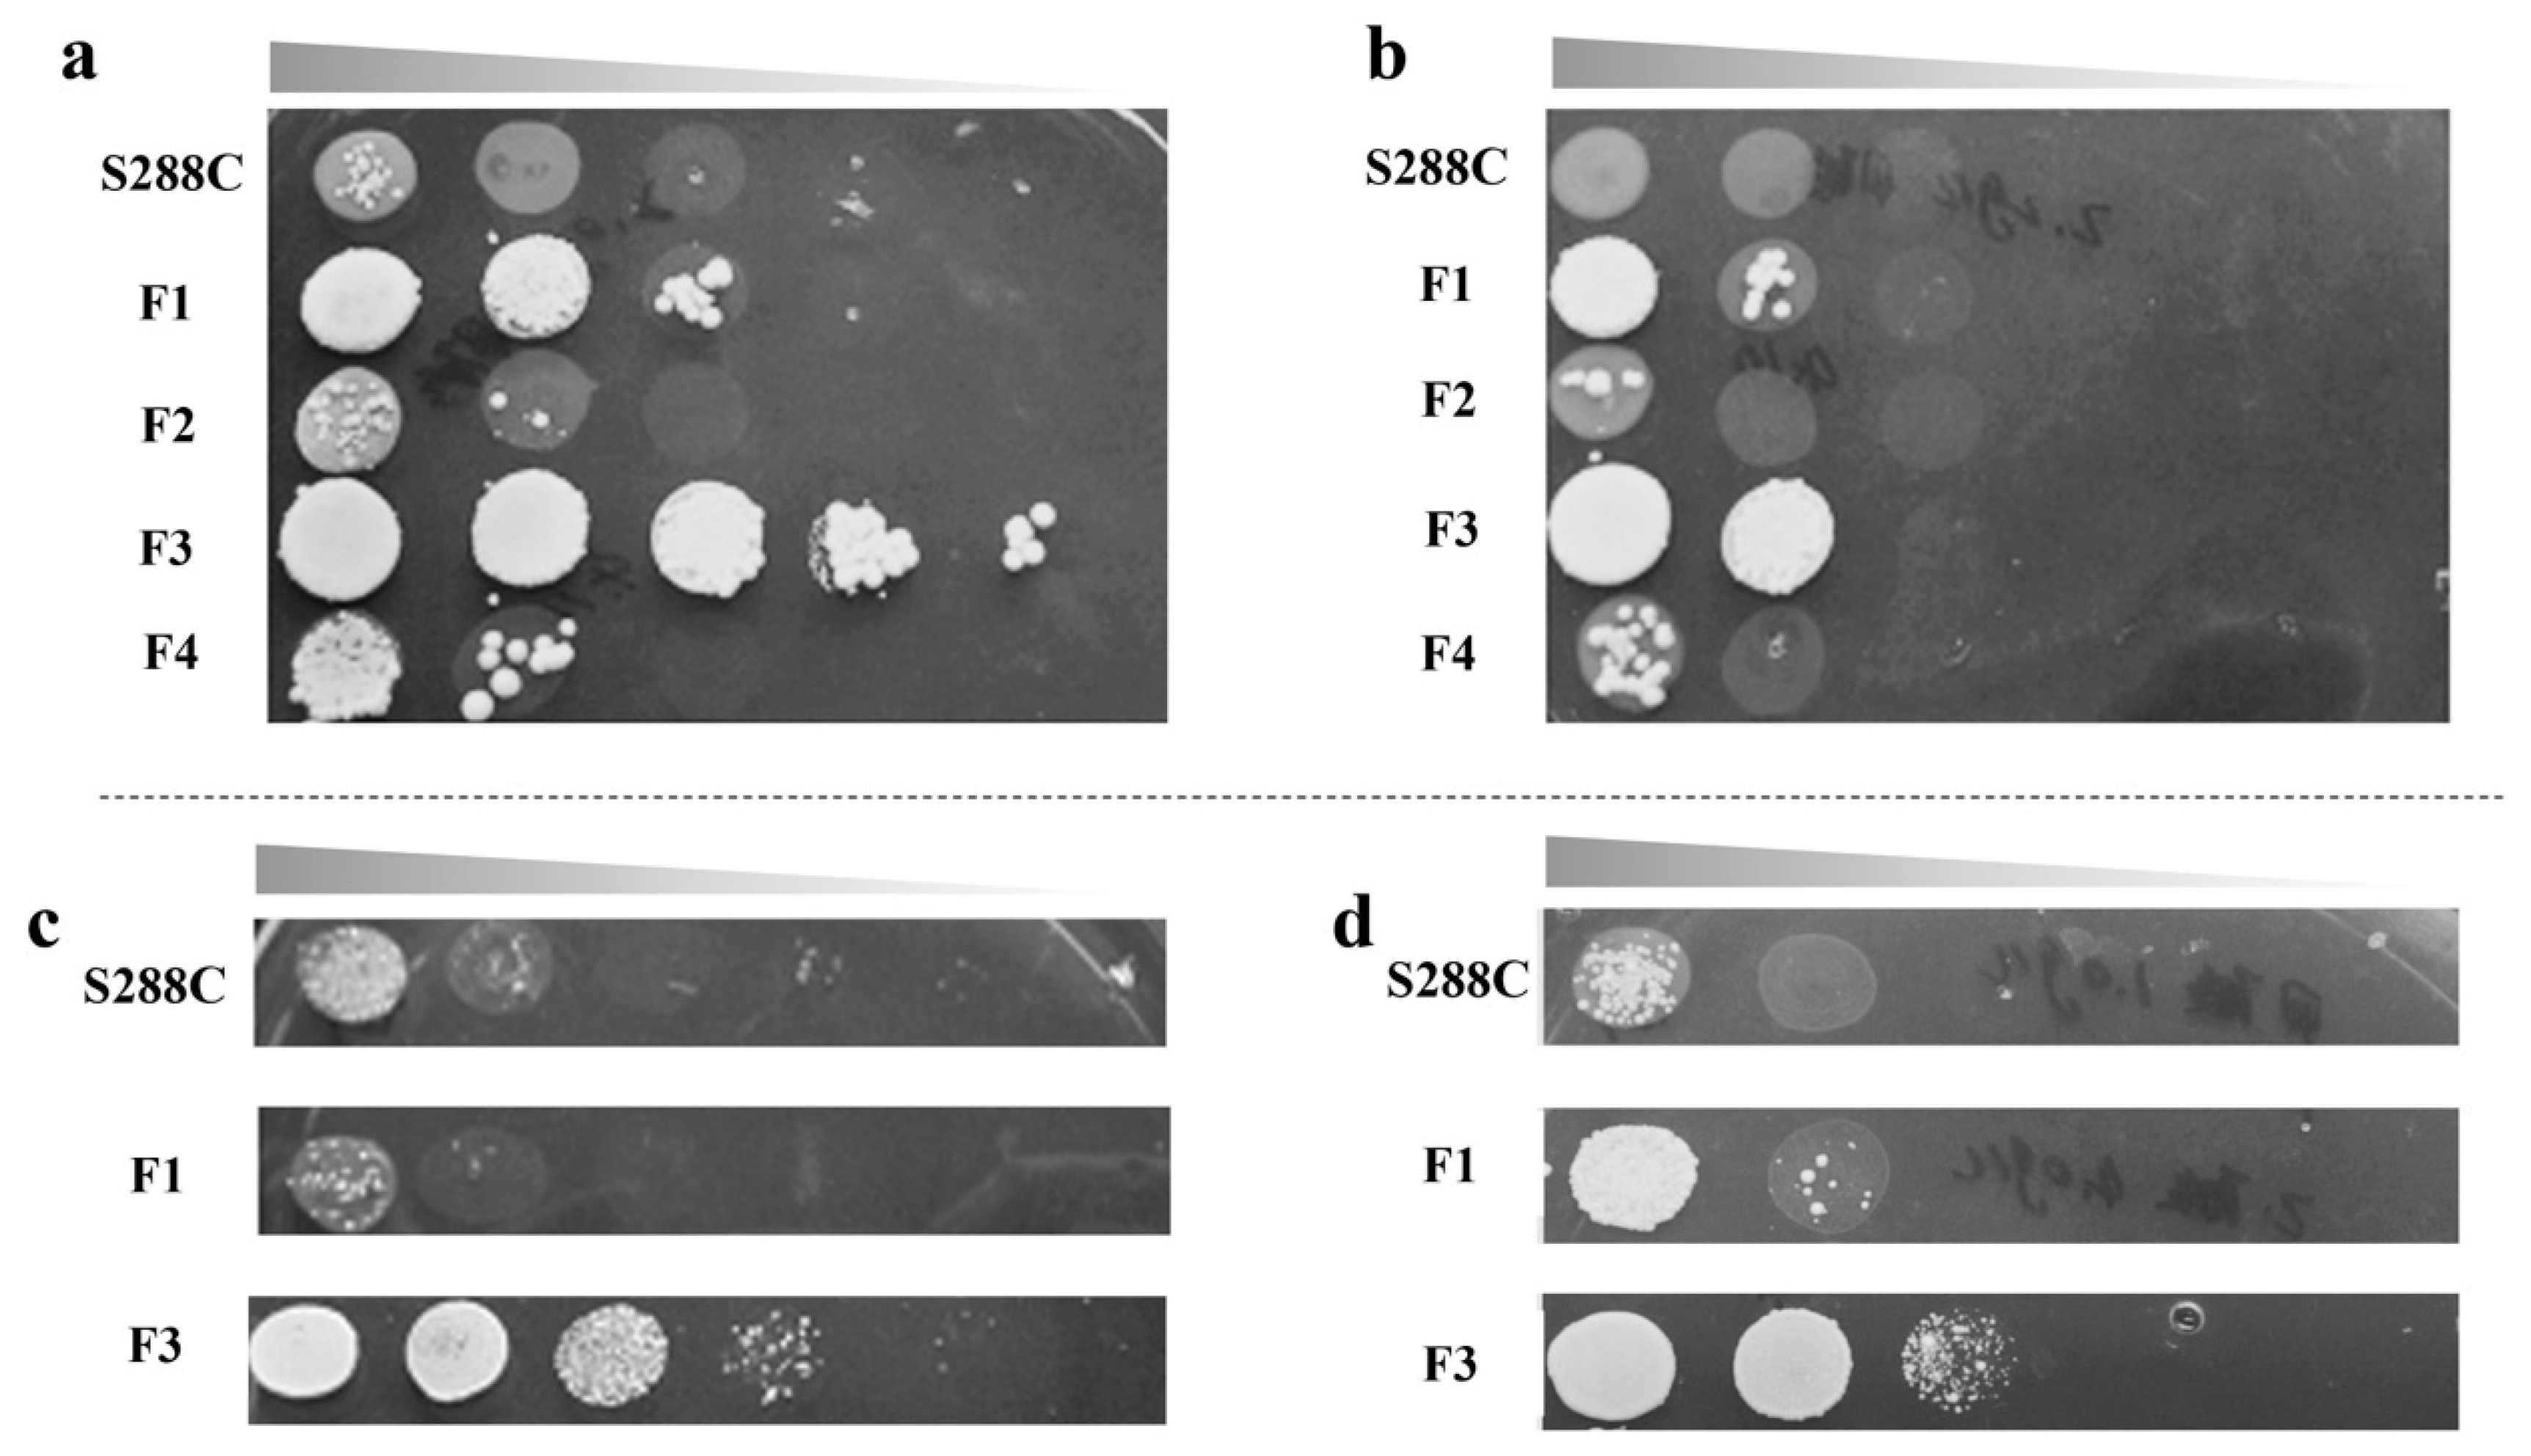

Formate Dehydrogenase Improves the Resistance to Formic Acid and Acetic Acid Simultaneously in Saccharomyces cerevisiae
Abstract
:1. Introduction
2. Results and Discussion
2.1. ALE and Cell Growth Test
2.2. Glucose Fermentation in the Presence of Inhibitors
2.3. Transcriptional Analysis of the Evolved Strain F3
2.4. fdh Overexpression Improved Tolerance to Formic Acid
2.5. fdh Overexpression Improved Tolerance to Acetic Acid
3. Materials and Methods
3.1. Strains and Media
3.2. ALE in the Formic Acid
3.3. Cell Growth Tests and Glucose Fermentation with Inhibitors
3.4. Transcriptional Analysis of Domesticated Strain F3
3.5. fdh Overexpression in S. cerevisiae and Inhibitors Tolerance Assessment
3.6. FDH1 Activity Assay
3.7. Determination of Cell Viability
3.8. Analytical Methods
Supplementary Materials
Author Contributions
Funding
Institutional Review Board Statement
Informed Consent Statement
Data Availability Statement
Conflicts of Interest
References
- Sarawan, C.; Suinyuy, T.N.; Sewsynker-Sukai, Y.; Kana, E.G. Optimized activated charcoal detoxification of acid-pretreated lignocellulosic substrate and assessment for bioethanol production. Bioresour. Technol. 2019, 286, 121403. [Google Scholar] [CrossRef]
- Phukoetphim, N.; Salakkam, A.; Laopaiboon, P.; Laopaiboon, L. Kinetic models for batch ethanol production from sweet sorghum juice under normal and high gravity fermentations: Logistic and modified Gompertz models. J. Biotechnol. 2017, 243, 69–75. [Google Scholar] [CrossRef] [PubMed]
- Ko, J.K.; Lee, J.H.; Jung, J.H.; Lee, S.-M. Recent advances and future directions in plant and yeast engineering to improve lignocellulosic biofuel production. Renew. Sustain. Energy Rev. 2020, 134, 110390. [Google Scholar] [CrossRef]
- Barak, S.; Rahman, R.K.; Neupane, S.; Ninnemann, E.; Arafin, F.; Laich, A.; Terracciano, A.C.; Vasu, S.S. Measuring the effectiveness of high-performance Co-Optima biofuels on suppressing soot formation at high temperature. Proc. Natl. Acad. Sci. USA 2020, 117, 3451–3460. [Google Scholar] [CrossRef]
- Sukai, Y.; Kana, E.G. Simultaneous saccharification and bioethanol production from corn cobs: Process optimization and kinetic studies. Bioresour. Technol. 2018, 262, 32–41. [Google Scholar] [CrossRef] [PubMed]
- Singh, A.; Bedore, S.R.; Sharma, N.K.; Lee, S.A.; Eiteman, M.A.; Neidle, E.L. Removal of aromatic inhibitors produced from lignocellulosic hydrolysates by Acinetobacter baylyi ADP1 with formation of ethanol by Kluyveromyces marxianus. Biotechnol. Biofuels 2019, 12, 91. [Google Scholar] [CrossRef]
- Cunha, J.T.; Costa, C.E.; Ferraz, L.; Romaní, A.; Johansson, B.; Sa-Correia, I.; Domingues, L. HAA1 and PRS3 overexpression boosts yeast tolerance towards acetic acid improving xylose or glucose consumption: Unravelling the underlying mechanisms. Appl. Microbiol. Biotechnol. 2018, 102, 4589–4600. [Google Scholar] [CrossRef]
- Kim, S.-K.; Jin, Y.-S.; Choi, I.-G.; Park, Y.-C.; Seo, J.-H. Enhanced tolerance of Saccharomyces cerevisiae to multiple lignocellulose-derived inhibitors through modulation of spermidine contents. Metab. Eng. 2015, 29, 46–55. [Google Scholar] [CrossRef]
- Cao, D.; Tu, M.; Xie, R.; Li, J.; Wu, Y.; Adhikari, S. Inhibitory Activity of Carbonyl Compounds on Alcoholic Fermentation by Saccharomyces cerevisiae. J. Agric. Food Chem. 2014, 62, 918–926. [Google Scholar] [CrossRef] [PubMed]
- Chen, Y.; Sheng, J.; Jiang, T.; Stevens, J.; Feng, X.; Wei, N. Transcriptional profiling reveals molecular basis and novel genetic targets for improved resistance to multiple fermentation inhibitors in Saccharomyces cerevisiae. Biotechnol. Biofuels 2016, 9, 9. [Google Scholar] [CrossRef] [Green Version]
- Palmqvist, E.; Hahn-Hägerdal, B. Fermentation of lignocellulosic hydrolysates. I: Inhibition and detoxification. Bioresour. Technol. 2000, 74, 17–24. [Google Scholar] [CrossRef]
- Wei, N.; Quarterman, J.; Kim, S.R.; Cate, J.H.; Jin, Y.-S. Enhanced biofuel production through coupled acetic acid and xylose consumption by engineered yeast. Nat. Commun. 2013, 4, 2580. [Google Scholar] [CrossRef] [PubMed] [Green Version]
- Parawira, W.; Tekere, M. Biotechnological strategies to overcome inhibitors in lignocellulose hydrolysates for ethanol production: Review. Crit. Rev. Biotechnol. 2011, 31, 20–31. [Google Scholar] [CrossRef]
- Guaragnella, N.; Bettiga, M. Acetic acid stress in budding yeast: From molecular mechanisms to applications. Yeast 2021, 38, 391–400. [Google Scholar] [CrossRef] [PubMed]
- Kim, M.S.; Cho, K.H.; Park, K.H.; Jang, J.; Hahn, J.-S. Activation of Haa1 and War1 transcription factors by differential binding of weak acid anions in Saccharomyces cerevisiae. Nucleic Acids Res. 2019, 47, 1211–1224. [Google Scholar] [CrossRef] [Green Version]
- Papapetridis, I.; van Dijk, M.; Dobbe, A.P.; Metz, B.; Pronk, J.T.; van Maris, A.J. Improving ethanol yield in acetate-reducing Saccharomyces cerevisiae by cofactor engineering of 6-phosphogluconate dehydrogenase and deletion of ALD6. Microb. Cell Fact. 2016, 15, 67–82. [Google Scholar] [CrossRef] [Green Version]
- Pampulha, M.E.; Loureiro-Dias, M.C. Energetics of the effect of acetic acid on growth of Saccharomyces cerevisiae. FEMS Microbiol. Lett. 2000, 184, 69–72. [Google Scholar] [CrossRef] [PubMed]
- Balderas-Hernández, V.E.; Correia, K.; Mahadevan, R. Inactivation of the transcription factor mig1 (YGL035C) in Saccharomyces cerevisiae improves tolerance towards monocarboxylic weak acids: Acetic, formic and levulinic acid. J. Ind. Microbiol. Biotechnol. 2018, 45, 735–751. [Google Scholar] [CrossRef] [PubMed]
- Gert, V.; Quinten, D.; Ward, V.; Arne, P.; Foulquié-Moreno, M.R.; Thevelein, J.M. A novel AST2 mutation generated upon whole-genome transformation of Saccharomyces cerevisiae confers high tolerance to 5-hydroxymethylfurfural (HMF) and other inhibitors. PLoS Genet. 2021, 16, e1009826. [Google Scholar]
- Fonseca, B.G.; Puentes, J.G.; Mateo, S.; Sánchez, S.; Moya, A.J.; Roberto, I.C. Detoxification of rice straw and olive tree pruning hemicellulosic hydrolysates employing Saccharomyces cerevisiae and its effect on the ethanol production by Pichia stipites. J. Agric. Food Chem. 2013, 61, 9658–9665. [Google Scholar] [CrossRef] [PubMed]
- Palma, M.; Guerreiro, J.F.; Sá-Correia, I. Adaptive Response and Tolerance to Acetic Acid in Saccharomyces cerevisiae and Zygosaccharomyces bailii: A Physiological Genomics Perspective. Front. Microbiol. 2018, 9, 274. [Google Scholar] [CrossRef] [PubMed]
- Sanda, T.; Hasunuma, T.; Matsuda, F.; Kondo, A. Repeated-batch fermentation of lignocellulosic hydrolysate to ethanol using a hybrid Saccharomyces cerevisiae strain metabolically engineered for tolerance to acetic and formic acids. Bioresour. Technol. 2011, 102, 7917–7924. [Google Scholar] [CrossRef]
- Almario, M.P.; Reyes, L.H.; Kao, K.C. Evolutionary engineering of Saccharomyces cerevisiae for enhanced tolerance to hydrolysates of lignocellulosic biomass. Biotechnol. Bioeng. 2013, 110, 2616. [Google Scholar] [CrossRef] [PubMed]
- Liu, Z.J.; Radi, M.; Mohamed, E.T.T.; Feist, A.M.; Dragone, G.; Mussatto, S.I. Adaptive laboratory evolution of Rhodosporidium toruloides to inhibitors derived from lignocellulosic biomass and genetic variations behind evolution. Bioresour. Technol. 2021, 333, 125171. [Google Scholar] [CrossRef]
- Antonovsky, N.; Gleizer, S.; Noor, E.; Zohar, Y.; Herz, E.; Barenholz, U.; Zelcbuch, L.; Amram, S.; Wides, A.; Tepper, N.; et al. Sugar Synthesis from CO2 in Escherichia coli. Cell 2016, 166, 115–125. [Google Scholar] [CrossRef] [PubMed] [Green Version]
- Pereira, S.R.; Nogué, V.S.i.; Frazão, C.J.R.; Serafim, L.S.; Gorwa-Grauslund, M.F.; Xavier, A.M.R.B. Adaptation of Scheffersomyces stipitis to hardwood spent sulfite liquor by evolutionary engineering. Biotechnol. Biofuels 2015, 8, 50. [Google Scholar] [CrossRef] [PubMed] [Green Version]
- Smith, J.; Van Rensburg, E.; Görgens, J.F. Simultaneously improving xylose fermentation and tolerance to lignocellulosic inhibitors through evolutionary engineering of recombinant Saccharomyces cerevisiae harboring xylose isomerase. BMC Biotechnol. 2014, 14, 41. [Google Scholar] [CrossRef] [PubMed] [Green Version]
- Zeng, L.; Huang, J.; Feng, P.; Zhao, X.; Si, Z.; Long, X.; Cheng, Q.; Yi, Y. Transcriptomic analysis of formic acid stress response in Saccharomyces cerevisiae. World J. Microbiol. Biotechnol. 2022, 38, 1–19. [Google Scholar] [CrossRef] [PubMed]
- Konzock, O.; Zaghen, S.; Norbeck, J. Tolerance of Yarrowia lipolytica to inhibitors commonly found in lignocellulosic hydrolysates. BMC Microbiol. 2021, 21, 77. [Google Scholar] [CrossRef]
- Oh, E.J.; Wei, N.; Kwak, S.; Kim, H.; Jin, Y.-S. Overexpression of RCK1 improves acetic acid tolerance in Saccharomyces cerevisiae. J. Biotechnol. 2019, 292, 1–4. [Google Scholar] [CrossRef] [PubMed]
- Molin, M.; Norbeck, J.; Blomberg, A. Dihydroxyacetone Kinases in Saccharomyces cerevisiaeAre Involved in Detoxification of Dihydroxyacetone. J. Biol. Chem. 2003, 278, 1415–1423. [Google Scholar] [CrossRef] [PubMed] [Green Version]
- Cheng, C.; Tang, R.-Q.; Xiong, L.; Hector, R.E.; Bai, F.-W.; Zhao, X.-Q. Association of improved oxidative stress tolerance and alleviation of glucose repression with superior xylose-utilization capability by a natural isolate of Saccharomyces cerevisiae. Biotechnol. Biofuels 2018, 11, 28. [Google Scholar] [CrossRef] [PubMed] [Green Version]
- Wolfger, H.; Mamnun, Y.M.; Kuchler, K. The Yeast Pdr15p ATP-binding Cassette (ABC) Protein Is a General Stress Response Factor Implicated in Cellular Detoxification. J. Biol. Chem. 2004, 279, 11593–11599. [Google Scholar] [CrossRef] [Green Version]
- Lee, Y.J.; Nasution, O.; Lee, Y.M.; Kim, E.; Choi, W.J.; Kim, W.K. Overexpression of PMA1 enhances tolerance to various types of stress and constitutively activates the SAPK pathways in Saccharomyces cerevisiae. Appl. Microbiol. Biotechnol. 2017, 101, 229–239. [Google Scholar] [CrossRef]
- Piper, M.D.; Hong, S.-P.; Ball, G.E.; Dawes, I.W. Regulation of the Balance of One-carbon Metabolism inSaccharomyces cerevisiae. J. Biol. Chem. 2000, 275, 30987–30995. [Google Scholar] [CrossRef] [PubMed] [Green Version]
- De La Cruz, J.G.; Machens, F.; Messerschmidt, K.; Bar-Even, A. Core Catalysis of the Reductive Glycine Pathway Demonstrated in Yeast. ACS Synth. Biol. 2019, 8, 911–917. [Google Scholar] [CrossRef]
- Sakihama, Y.; Hasunuma, T.; Kondo, A. Improved ethanol production from xylose in the presence of acetic acid by the overexpression of the HAA1 gene in Saccharomyces cerevisiae. J. Biosci. Bioeng. 2015, 119, 297–302. [Google Scholar] [CrossRef] [PubMed]
- Min, K.; Park, Y.-S.; Park, G.W.; Lee, J.-P.; Moon, M.; Ko, C.H.; Lee, J.-S. Elevated conversion of CO2 to versatile formate by a newly discovered formate dehydrogenase from Rhodobacter aestuarii. Bioresour. Technol. 2020, 305, 123155. [Google Scholar] [CrossRef] [PubMed]
- Overkamp, K.M.; Kötter, P.; Van Der Hoek, R.; Schoondermark-Stolk, S.; Luttik, M.A.H.; Van Dijken, J.P.; Pronk, J.T. Functional analysis of structural genes for NAD+-dependent formate dehydrogenase inSaccharomyces cerevisiae. Yeast 2002, 19, 509–520. [Google Scholar] [CrossRef]
- El-Zahab, B.; Donnelly, D.; Wang, P.J.B. Particle-tethered NADH for production of methanol from CO2 catalyzed by coimmobilized enzymes. Biotechnol. Bioeng. 2008, 99, 508–514. [Google Scholar] [CrossRef]
- Barin, R.; Biria, D.; Rashid-Nadimi, S.; Asadollahi, M.A. Enzymatic CO2 reduction to formate by formate dehydrogenase from Candida boidinii coupling with direct electrochemical regeneration of NADH. J. CO2 Util. 2018, 28, 117–125. [Google Scholar] [CrossRef]
- Choe, H.; Joo, J.C.; Cho, D.H.; Kim, M.H.; Lee, S.H.; Jung, K.-D.; Kim, Y.H. Efficient CO2-Reducing Activity of NAD-Dependent Formate Dehydrogenase from Thiobacillus sp. KNK65MA for Formate Production from CO2 Gas. PLoS ONE 2014, 9, e103111. [Google Scholar] [CrossRef] [PubMed]
- Rie, M.; Yutaka, A. Bio-CO2 fixation with formate dehydrogenase from Saccharomyces cerevisiae and water-soluble zinc porphyrin by visible light. Biotechnol. Lett. 2002, 24, 1931–1934. [Google Scholar]
- Ferguson, S.J. ATP synthase: From sequence to ring size to the P/O ratio. Proc. Natl. Acad. Sci. USA 2010, 107, 16755–16756. [Google Scholar] [CrossRef] [Green Version]
- van Rossum, H.M.; Kozak, B.U.; Pronk, J.T.; van Maris, A.J.A. Engineering cytosolic acetyl-coenzyme A supply in Saccharomyces cerevisiae: Pathway stoichiometry, free-energy conservation and redox-cofactor balancing. Metab. Eng. 2016, 36, 99–115. [Google Scholar] [CrossRef] [PubMed]
- Ding, J.; Holzwarth, G.; Penner, M.H.; Patton-Vogt, J.; Bakalinsky, A.T. Overexpression of acetyl-CoA synthetase in Saccharomyces cerevisiae increases acetic acid tolerance. FEMS Microbiol Lett. 2015, 362, 1–7. [Google Scholar] [CrossRef] [PubMed] [Green Version]
- Li, Y.-J.; Wang, M.-M.; Chen, Y.-W.; Wang, M.; Fan, L.-H.; Tan, T.-W. Engineered yeast with a CO2-fixation pathway to improve the bio-ethanol production from xylose-mixed sugars. Sci. Rep. 2017, 7, 43875. [Google Scholar] [CrossRef] [Green Version]

| Gene | log2FC | Description |
|---|---|---|
| RCK1 [30] | 7.89 | Protein kinase involved in the response to oxidative stress |
| DAK2 [31] | 4.21 | Required for detoxification of dihydroxyacetone (DHA), involved in stress adaptation |
| CTT1 [10,32] | 3.10 | Has a role in protection from oxidative damage by hydrogen peroxide |
| PDR15 [33] | 2.81 | Multidrug transporter and general stress response factor implicated in cellular detoxification |
| FDH1 [18] | 2.15 | May protect cells from exogenous formate |
| PMA1 [34] | 2.10 | Pump protons out of cell, major regulator of cytoplasmic pH and plasma membrane potential |
| Strain | Activity (U/mg) | Medium |
|---|---|---|
| S. cerevisiae S288C | 1.10 ± 0.16 | YPD |
| S. cerevisiae F3 | 2.83 ± 0.11 | YPD |
| Control | 1.29 ± 0.09 | SD |
| S. cerevisiae FA | 3.06 ± 0.21 | SD |
| Strain | Formic Acid Concentration (mg/L) |
|---|---|
| Control | ND |
| S. cerevisiae FA | 31 ± 1 |
Publisher’s Note: MDPI stays neutral with regard to jurisdictional claims in published maps and institutional affiliations. |
© 2022 by the authors. Licensee MDPI, Basel, Switzerland. This article is an open access article distributed under the terms and conditions of the Creative Commons Attribution (CC BY) license (https://creativecommons.org/licenses/by/4.0/).
Share and Cite
Du, C.; Li, Y.; Xiang, R.; Yuan, W. Formate Dehydrogenase Improves the Resistance to Formic Acid and Acetic Acid Simultaneously in Saccharomyces cerevisiae. Int. J. Mol. Sci. 2022, 23, 3406. https://doi.org/10.3390/ijms23063406
Du C, Li Y, Xiang R, Yuan W. Formate Dehydrogenase Improves the Resistance to Formic Acid and Acetic Acid Simultaneously in Saccharomyces cerevisiae. International Journal of Molecular Sciences. 2022; 23(6):3406. https://doi.org/10.3390/ijms23063406
Chicago/Turabian StyleDu, Cong, Yimin Li, Ruijuan Xiang, and Wenjie Yuan. 2022. "Formate Dehydrogenase Improves the Resistance to Formic Acid and Acetic Acid Simultaneously in Saccharomyces cerevisiae" International Journal of Molecular Sciences 23, no. 6: 3406. https://doi.org/10.3390/ijms23063406
APA StyleDu, C., Li, Y., Xiang, R., & Yuan, W. (2022). Formate Dehydrogenase Improves the Resistance to Formic Acid and Acetic Acid Simultaneously in Saccharomyces cerevisiae. International Journal of Molecular Sciences, 23(6), 3406. https://doi.org/10.3390/ijms23063406

